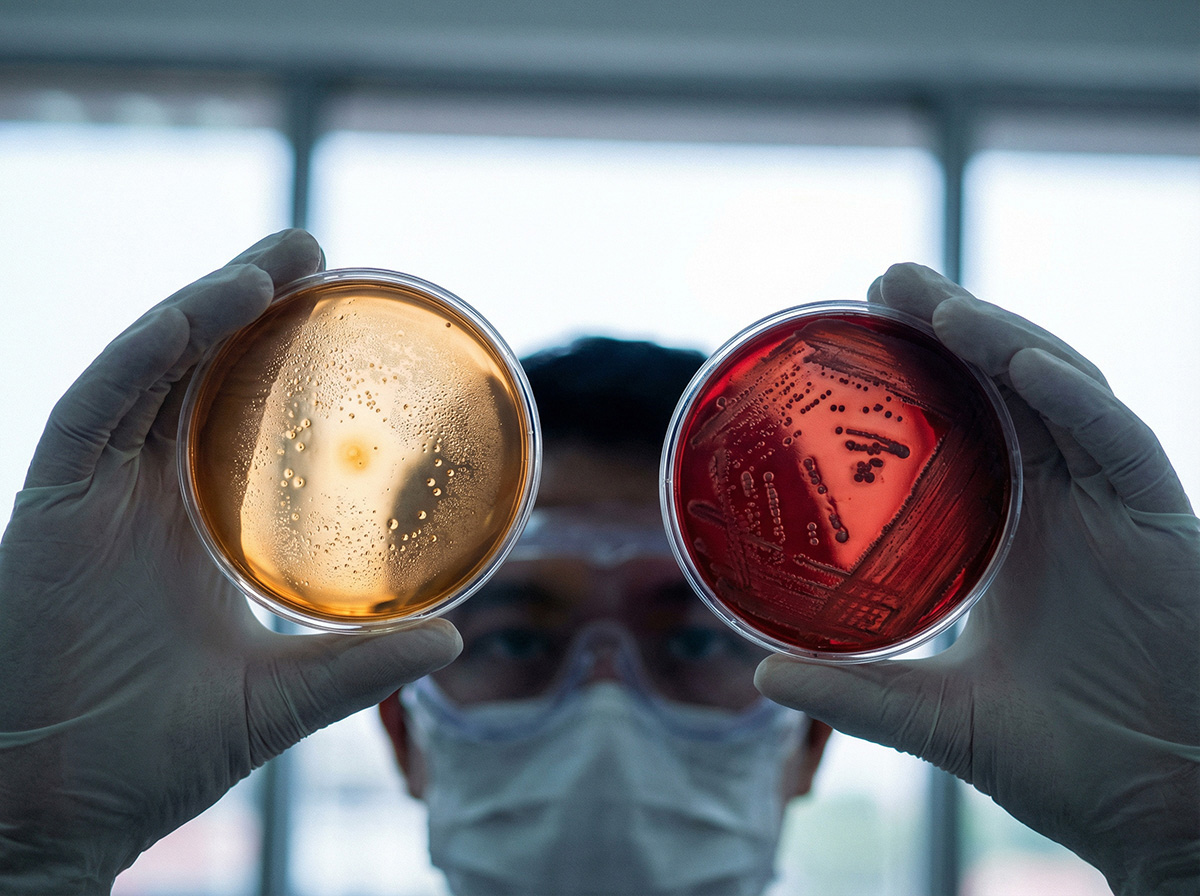

Individuelle und kreative Bildwelten
Ihre Herausforderung
Strenge Regularien, komplexe Inhalte und sensible Zielgruppen stehen heute einem Bedarf an visuellem Content gegenüber, der sich ständig ändern muss und neu ist. Der Content soll trotzdem über alle Kanäle hinweg skalierbar sein.
Vor allem bei Bildern, Videos und Illustrationen stoßen dabei traditionelle Lösungen wie Stockbilder oder aufwändige Einzelproduktionen schnell an ihre Grenzen: sie sind entweder zu austauschbar oder zu teuer. Mit der revolutionären Bildgenerierung durch KI bieten sich jetzt aber ganz neue Möglichkeiten.
Dafür haben wir bei Hennig ein eigenes Kompetenzzentrum geschaffen: unser KI-Studio Metafusionlab. Wir generieren Bilder, Illustrationen und Videos auf höchstem Niveau, die Ihre Botschaften verständlich, visuell konsistent und überraschend kreativ vermitteln. Dabei bleiben selbst komplexe Kreationen im Kostenrahmen.
Ihre Herausforderung
Strenge Regularien, komplexe Inhalte und sensible Zielgruppen stehen heute einem Bedarf an visuellem Content gegenüber, der sich ständig ändern muss und neu ist. Der Content soll trotzdem über alle Kanäle hinweg skalierbar sein.
Vor allem bei Bildern, Videos und Illustrationen stoßen dabei traditionelle Lösungen wie Stockbilder oder aufwändige Einzelproduktionen schnell an ihre Grenzen: sie sind entweder zu austauschbar oder zu teuer. Mit der revolutionären Bildgenerierung durch KI bieten sich jetzt aber ganz neue Möglichkeiten.
Dafür haben wir bei Hennig ein eigenes Kompetenzzentrum geschaffen: unser KI-Studio Metafusionlab. Wir generieren Bilder, Illustrationen und Videos auf höchstem Niveau, die Ihre Botschaften verständlich, visuell konsistent und überraschend kreativ vermitteln. Dabei bleiben selbst komplexe Kreationen im Kostenrahmen.
Alles aus einer Hand
Strategie, Kampagnen und KI-Visuals
Seit 25 Jahren unterstützen wir Unternehmen aus der Pharmaindustrie, Hersteller von Medizinprodukten, Kliniken und Apotheken und haben für sie eine beachtliche Bandbreite von Lösungen entwickelt: Broschüren, Vertriebsunterlagen, Magazine, Anzeigen, Webseiten und Apps, um nur ein paar zu nennen. Unsere Erfahrung im Bereich Healthcare vereinfacht und beschleunigt die damit verbundenen Prozesse und Abläufe.
Dafür schlägt unser Herz:
Ihr Unternehmen, Ihr Produkt oder Ihre Visuals werden optimal aufeinander abgestimmt für optimalen Impact bei maximaler Konsistenz.
Alles aus einer Hand
Strategie, Kampagnen und KI-Visuals
Seit 25 Jahren unterstützen wir Unternehmen aus der Pharmaindustrie, Hersteller von Medizinprodukten, Kliniken und Apotheken und haben für sie eine beachtliche Bandbreite von Lösungen entwickelt: Broschüren, Vertriebsunterlagen, Magazine, Anzeigen, Webseiten und Apps, um nur ein paar zu nennen. Unsere Erfahrung im Bereich Healthcare vereinfacht und beschleunigt die damit verbundenen Prozesse und Abläufe.
Dafür schlägt unser Herz:
Ihr Unternehmen, Ihr Produkt oder Ihre Visuals werden optimal aufeinander abgestimmt für optimalen Impact bei maximaler Konsistenz.
Unsere Leistungsmodule
KI-Bilder für Kampagnen & Content
Key Visuals, Motive für die Socials, Headerbilder und Illustrationen für wissenschaftliche Kommunikation.
Ideal für: Kampagnen, Disease Awareness, Websites, Broschüren, interne Kommunikation.
KI-Motion & Video
Erklär-Loops, animierte Visuals, Clips für Socials und Content für E-Learning, interne Kommunikation und HCP-Kommunikation.
Ideal für: Wirkmechanismen, Abläufe, Services, Studienergebnisse.
Hybrid-Produktionen (Real + KI)
Kombination von realen Produkten, Packshots oder Studioaufnahmen mit KI-generierten Hintergründen, Szenen und virtuellen Systemen.
Ideal für: Kampagnen, Produktwelten, Image- und Markenstories – in höchster Qualität zu budget-freundlichen Preisen.
User Cases
Patient:innen- & Angehörigenkommunikation
Disease Awareness, Prävention, Therapieaufklärung – Bildwelten, die informieren, ohne zu dramatisieren.
Fachkreis- & HCP-Kommunikation
Kongressauftritte, Schulungsmaterialien, Außendienst-Flyer und Dokumente – also visuelle Unterstützung für Vertrieb, Medical und Training.
Apotheken- & POS-Konzepte
Plakate, Displays, Screens und Social-Pakete für Apotheken und Kooperationen – schnell adaptierbar, einheitlich im Look. KI-Visuals erlauben schnelle Anpassungen an Märkte, Sprachen oder Seasons, ohne jedes Mal ein neues Shooting aufzusetzen.
Always on: Kommunikation & Corporate Content
Regelmäßig erneuerter Content für Websites, Social Media, Newsletter und interne Kanäle – auf Basis definierter Bildwelten.
Wissenschafts- & Forschungskommunikation
Wir machen medizinische und wissenschaftliche Inhalte sichtbar – für Fachkreise, Entscheidungsträger und Öffentlichkeit.
Wir schaffen Visuals, die fachlich und visuell überzeugen – für Forschung, Ausbildung und Healthcare-Kommunikation
Bild- & Videowelten für Pharma & Healthcare
In unserer Galerie zeigen wir exemplarisch KI-basierte Bild- und Bewegtbildwelten aus verschiedenen Bereichen. Filtern Sie nach Themen – und sehen Sie, wie wir komplexe Inhalte in klare Visuals übersetzt haben.
Jedes Motiv ist ein Beispiel dafür, wie wirkungsstark KI-Bildproduktion und KI-Motion gezielt für Healthcare- und Wissenschaftskommunikation sein können.
Qualität, Sicherheit & Regulatorik
Kommunikation, die fachlich stimmt – und formal Bestand hat.
Erfahrung im Gesundheitsmarkt
Zusammenarbeit mit Pharma, Kliniken, Apotheken und Forschung.
Med/Legal-kompatible Visuals
Bildwelten, die sich in Ihre Regulatory- und Legal-Workflows integrieren lassen – mit klarer Dokumentation.
Datenschutz & Persönlichkeitsrechte
Sicherer Einsatz von KI-Personen und realen Models auf Basis transparenter Vereinbarungen.
Transparente Nutzungsrechte
Klare Regelungen zu Kanälen, Laufzeiten und Ländern – verbindlich im Angebot dokumentiert.
Unser Prozess
Briefing & Zieldefinition
Definieren von Zielen, Zielgruppen, Kanälen und regulatorischen Rahmenbedingungen
Konzept & Visual Strategy
Kampagnenidee, Leit-Visuals und Bildwelten entwickeln – inklusive erster KI-Entwürfe.
Produktion & Umsetzung
KI-Bildproduktion, KI-Motion und Hybrid-Produktionen – abgestimmt auf Ihre Freigabeprozesse.
Roll-Out & Weiterentwicklung
Ausspielung in Kampagnen, Content-Plänen und Kanälen – auf Wunsch als laufende Content-Partnerschaft.
Ein klarer Prozess – von der ersten Idee bis zur laufenden Content-Pipeline.
Lassen Sie uns über Ihr nächstes Projekt sprechen.
Lassen Sie uns über Ihr nächstes Projekt sprechen.
FAQ – Häufige Fragen zu KI & Pharma
Dürfen wir KI-Bilder in der Pharmakommunikation überhaupt einsetzen?
Ja – entscheidend ist, wie sie eingesetzt werden.
Wir entwickeln Visuals, die in Ihre Regularien passen und mit Ihren Med-/Legal-Teams abgestimmt werden können.
KI ist für uns ein Produktionswerkzeug, kein Selbstzweck.
Wie stellen Sie sicher, dass Darstellungen medizinisch korrekt sind?
Wir arbeiten auf Basis Ihrer Daten, Fachinformationen und Briefings.
Auf Wunsch binden wir interne Expert:innen oder externe Fachpersonen in Konzeption und Prüfung ein.
Wie sieht es mit Nutzungsrechten aus?
Sie erhalten klar definierte Nutzungsrechte für die vereinbarten Kanäle, Länder und Zeiträume.
Diese Rechte werden im Angebot transparent aufgeführt.
Was ist mit Datenschutz?
Wir verarbeiten keine sensiblen Patientendaten, sofern nicht ausdrücklich vereinbart.
Wenn reale Personen gezeigt werden, geschieht das auf Basis rechtskonformer Einwilligungen und Model-Releases.
Können wir klein starten?
Ja. Viele Projekte beginnen mit einem klar abgegrenzten Piloten – z. B. einer Disease-Awareness-Strecke oder HCP-Contentreihe –, die wir gemeinsam auswerten und skalieren.
FAQ – Häufige Fragen zu KI & Pharma
Dürfen wir KI-Bilder in der Pharmakommunikation überhaupt einsetzen?
Ja – entscheidend ist, wie sie eingesetzt werden.
Wir entwickeln Visuals, die in Ihre Regularien passen und mit Ihren Med-/Legal-Teams abgestimmt werden können.
KI ist für uns ein Produktionswerkzeug, kein Selbstzweck.
Wie stellen Sie sicher, dass Darstellungen medizinisch korrekt sind?
Wir arbeiten auf Basis Ihrer Daten, Fachinformationen und Briefings.
Auf Wunsch binden wir interne Expert:innen oder externe Fachpersonen in Konzeption und Prüfung ein.
Wie sieht es mit Nutzungsrechten aus?
Sie erhalten klar definierte Nutzungsrechte für die vereinbarten Kanäle, Länder und Zeiträume.
Diese Rechte werden im Angebot transparent aufgeführt.
Was ist mit Datenschutz?
Wir verarbeiten keine sensiblen Patientendaten, sofern nicht ausdrücklich vereinbart.
Wenn reale Personen gezeigt werden, geschieht das auf Basis rechtskonformer Einwilligungen und Model-Releases.
Können wir klein starten?
Ja. Viele Projekte beginnen mit einem klar abgegrenzten Piloten – z. B. einer Disease-Awareness-Strecke oder HCP-Contentreihe –, die wir gemeinsam auswerten und skalieren.